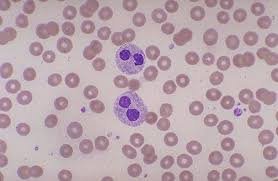
ZiadHab13893248's profile picture. Hemepath ❤️

Gutman Library at Thomas Jefferson University
@GutmanLibrary
News from the Paul J. Gutman Library of Thomas Jefferson University - East Falls Campus
You might like
👋 Hey there, Rams! We can't wait for a new year with @JeffersonUniv students -- don't forget we're always here for a quiet place to study, course materials & resources, help with your research, and more. You got this, and we're here to help!

Have questions about evidence synthesis? Drop in to chat with Jefferson librarians on November 14, 10-11am, about systematic reviews, scoping reviews, rapid reviews, umbrella reviews, and more. Drop in here: Jefferson.zoom.us/j/93226488335

Celebrate with us tomorrow (Wed, 10/22) from 12-2 for games and prizes as we celebrate #OpenAccessWeek #oaweek
It's Open Access Week! Celebrate with us & @GutmanLibrary with games, prizes, and giveaways. We'll kick off with games at Scott today at 12pm. Learn about open access: jefflibraries.libguides.com/blogs/ACNews/c… #OpenAccess #oaweek

SOS! Save Our Silks! Join our friends in the Textile & Costume Collection/Design Center on Thursday, Oct 23, 12:30 - 2pm to help us make storage for our printed silk textiles. RSVP required: jefferson.libcal.com/event/15530338

Join us on Thursday, Oct 9, at 5:30 for the Launch Party & Reading of "EVANESCENT ISSUE 6: Growing. Learning. Aging." Learn more: jefflibraries.libguides.com/blogs/ACNews/e…

Submit your research as art by Oct 17 to win $250! Details 👇
The competition is ON! @JeffersonUniv "Research as Art" contest is accepting submissions until Oct 17. Submit an image of your research for a chance to win $250. Learn more: jefflibraries.libguides.com/blogs/ACNews/r…

🔊Your feedback matters! Take a moment to fill out our quick suggestion form — it’s your chance to tell us what’s working, what could be better, and what you'd love to see at Gutman Library. jefferson.libwizard.com/f/Suggestion

Discover the Beauty of the Past at “The Lingerie Dress” Exhibit Opening on September 25 in Hayward Hall. Learn more: jefflibraries.libguides.com/blogs/ACNews/d… @JeffersonUniv

Stop by our main floor to check out "The Textile Color Card Association of the United States" display cases. The offers a fascinating glimpse into the origins of standardized color in the American textile and fashion industries. @JeffersonUniv Learn more:jefflibraries.libguides.com/blogs/ACNews/n…

Join us tonight at 5pm for the 1st session of "Cite now so you don't cry later." Can't make it tonight? Join us tomorrow or Wednesday! More info: jefferson.libcal.com/event/15176747
Hate managing your citations? Spend 30 minutes setting up citation software & save yourself hours later. Join us for a session (online or in person) offered Sept 8 - 11. Register: jefferson.libcal.com/calendar/Acade… #citationmanagement #collegewriting

Hate managing your citations? Spend 30 minutes setting up citation software & save yourself hours later. Join us for a session (online or in person) offered Sept 8 - 11. Register: jefferson.libcal.com/calendar/Acade… #citationmanagement #collegewriting

⚠️New Exhibit Alert!⚠️ Check out "The Textile Color Card Association of the United States" on the Main Floor. This exhibit offers a fascinating glimpse into the origins of standardized color in the American textile and fashion industries. @JeffersonUniv @JSTOR


Hate managing your citations? Spend 30 minutes setting up citation software & save yourself hours later. Join us for a session from Sept 8 - 11 in the Library's Library Instruction Space (LIS) on the Main Floor, or join us on Zoom.jefferson.libcal.com/calendar/Acade…

This May, we’re adding 25 eBooks to our collection that cover a wide range of topics, including innovation in the fashion industry, an infectious disease handbook, and the hidden costs of global warming. Check them out: jefflibraries.libguides.com/blogs/ACNews/2… #ebooks

25 New eBooks this April: Topics include a Biography of Angela Davis, Social Anxiety, Architectural Research, etc. Check them out: jefflibraries.libguides.com/blogs/ACNews/2… #ebooks

We recently acquired new resources from @jstor and they offer something for everyone – with databases on topics ranging from life sciences to history to sustainable development and more. Check them out: jefflibraries.libguides.com/blogs/ACNews/n…

Jump into our 25 new eBooks this March - topics include artificial intelligence, breastfeeding management, Hawaii colonialism, and more. Check them out: jefflibraries.libguides.com/blogs/ACNews/2… #ebooks #artificialinteliigence #breastfeedingmanagement

Educators: Jump into 2025 with a challenge! Today kicks off Ally Awareness Week and the Fix Your Content Contest. From now until Jan 15, log in to Canvas, make "fixes" to your content, and win prizes! MORE: jefflibraries.libguides.com/blogs/ACNews/a…
CHALLENGE ACCEPTED! It's Ally Awareness Week & the Fix Your Content Contest now until January 15. Educators - log in to Canvas, make "fixes" to your content, and win prizes. MORE: jefflibraries.libguides.com/blogs/ACNews/a… @Learning_Ally @Canvas_by_Inst #accessibility #ally #fixyourcontent

⏳ As our bicentennial year ends, we will seal our Bicentennial Time Capsule, celebrating Jefferson’s history and the community shaping our future. Filled with meaningful items, it won’t be opened again until 2074. Here’s to 200 years of improving lives! #Jefferson200

Enjoy pizza & prizes on Thursday at SOS: Save Our Silks! Help us make better storage for our printed silk textiles. RSVP by emailing [email protected]

United States Trends
- 1. Happy Thanksgiving Eve 3,574 posts
- 2. Good Wednesday 27.1K posts
- 3. #wednesdaymotivation 4,350 posts
- 4. #Wednesdayvibe 2,142 posts
- 5. Nuns 7,312 posts
- 6. Colorado State 3,128 posts
- 7. Mora 21K posts
- 8. Stranger Things Day 2,987 posts
- 9. Hump Day 10.4K posts
- 10. Happy Hump 6,845 posts
- 11. Luka 68.8K posts
- 12. Food Network N/A
- 13. Hong Kong 52.3K posts
- 14. Karoline Leavitt 25.1K posts
- 15. Clippers 19.9K posts
- 16. El Salvador 47.8K posts
- 17. Tina Turner 4,935 posts
- 18. Joy Reid 4,661 posts
- 19. Collar 47K posts
- 20. Witkoff 179K posts
Something went wrong.
Something went wrong.